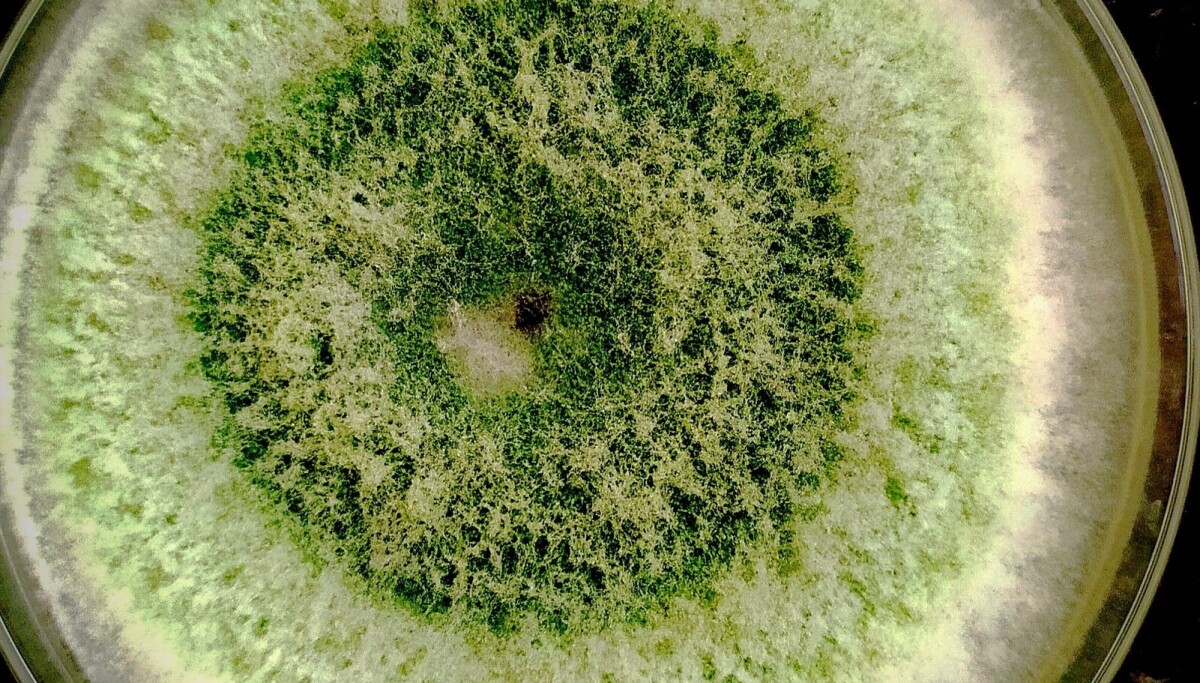

- Ble medlem
- 19.09.2014
- Innlegg
- 24.016
- Antall liker
- 17.229
Tilsvarer i snitt under to halvlitere butikkpils om dagen, så at en person drikker det i løpet av et år er jo en del, men ikke avsindig mye akkurat, men som snitt for en nasjon er det nok godt i øvre sjikt.Danskene drikker 12 l. alkohol i året....